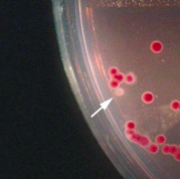

What are the 7 causes of inflammatory diarrhea?
- EHEC (enterohemorrhagic E. coli)
- EIEC (enteroinvasive)
- Shigella
- Salmonella: enterica and enteritidis
- Campylobacter jejuni
- Clostridium difficile
- Yersinia enterocolitica
What are the 6 causes of non-inflammatory diarrhea?
- ETEC (enterotoxigenic)
- EAEC (enteroaggregative)
- EPEC (enteropathogenic)
- Vibrio: cholera, parahemolyticus, and vulnificus
- S. aureus
- Bacillus cereus
What are th 5 anaerobes?
- Bacteroides fragilis
- Prevotella
- Clostridium perfringens
- Tetani
- Botulinum difficile
What is the MCC of infectious diarrhea?
- 90% of infectious diarrheas are caused by VIRUSES
What should you think about when a pt presents with persistent diarrhea (>10-14d)? Chronic?
- PERSISTENT: more likely to be a parasite, rather than a bacterial or viral cause
- CHRONIC: start considering HIV status
1. Diarrhea is a big problem with AIDS pts: can get HIV-associated diarrhea w/or w/o other opportunistic infection
2. Mycobacterium avium intracellulare, CMV
What are the definitions of acute and chronic diarrhea?
- ACUTE: 3 or more loose stools/day lasting <2 wks
- CHRONIC: persists greater than 4 weeks
What is inflammatory diarrhea?
- BLOODY diarrhea, aka dysentery
1. WBCs and RBCs seen in stool
2. Fever is common
3. Small volume diarrhea
4. Colon is commonly affected, but not always just the colon
What is non-inflammatory diarrhea?
- WATERY diarrhea
1. No cells in stool
2. Usually afebrile
3. Large volume diarrhea
4. Small intestine is commonly affected
What are the general characteristics of Shigella, E. coli, and Salmonella?
- G(-), facultative, anaerobic rods
1. Ferment glu w/acid production
2. Oxidase (-)
3. Reduce nitrates to nitrites (dipstick test)
4. Motile (except Shigella) - Antigenic structures used in serotyping: H (flagellar) Ag’s & O Ag’s -> O-side chain (polysaccharide) of LPS
- E. coli are part of normal flora: most do NOT cause disease b/c lack pathogenicity associated island (PAI)
What are the 3 types, and transmission of Shigella?
- G(-), non-motile, non-lactose fermenting, does not produce H2S
1. S. dysenteriae: Central/S. America epidemics
2. S. sonnei: 70% of US cases (mostly kids)
3. S. flexneri: 2nd most comm in US (most comm worldwide) - Highly transmissible (very low infectious dose) via fecal-oral or contaminated water/food
1. Daycare centers, migrant workers, travelers to developing countries, nursing homes

What is the pathogenesis of Shigella?
- Resistant to acidic environment of stomach, and taken up by epithelial cells (M cells) in the intestine
- Proliferate IC, escape into lamina propria, and are phagocytosed by macros that then apoptose
- Inflam response damages epi and allows bac to gain access to colonic epi cells -> invasion
- Spreads into adjacent cells via bacterium-induced, membrane-bound protrusions from the surface of the host cell -> formation of these protrusions depends on cellular actin polymerization proteins called formins (F-actin polymerization b/c non-motile bac)
1. Bacterium lyses membranes that surround it, freeing itself into the cytoplasm of the new cell

What are the clinical manifestations (and complications) of Shigella? Tx?
- CLINICAL: 1-wk incubation period
1. Self-limited diarrhea, fever, & abdominal pain lasting about 1 week
2. Initially watery diarrhea, but progresses to dysentery (bloody) in 50%
3. Some adults will have a subacute course that lasts several weeks (less common) - COMPLICATIONS: reactive arthritis, urethritis, conjunctivitis (Reiter’s)
1. Hemolytic uremic syndrome (HUS) may occur after infection with S. dysenteriae that produces Shiga toxin (AB toxin) - TX: Ceftriaxone, Ciprofloxacin, Azithromycin -> AB’s shorten the course and reduces duration of organism shedding in stools
What is unique about Enterohemorrhagic E. coli? Causes?
- Aka, STEC: Shiga toxin producing E. coli
1. Produce Shiga-like toxins – clinical symptoms similar to Shigellosis (S. dysenteriae)
2. Hemorrhagic colitis - Can’t ferment sorbitol (can be differentiated from other E. coli)
- Categorized as 0157:H7 and non-0157:H7 (both may cause severe illness)
- Caused by ingesting inadequately cooked meat (hamburgers), contaminated vegetables and milk; also human-to-human
1. Low infectious dose
2. Hospitalization required in 25-50% of patients
What are the 2 key pathogenetic mechs of EHEC?
- Locus of Enterocyte Effacement (LEE):
1. PAI
2. Type III secretion system that delivers E. coli receptor to host cell
3. Pedestal formation 4 attachment -> attaching and effacing lesion
4. Responsible for the diarrhea - Shiga toxin acts by removing an adenine from large (28S) ribosomal RNA, stopping protein synthesis
What is the clinical presentation of EHEC?
- Little fever, acute onset cramps, + watery diarrhea
- Diarrhea becomes bloody (hemorrhagic colitis) w/in 24 hours, and lasts up to 8 days (quite a long time)
1. O157:H7 strains more likely to cause large outbreaks, bloody diarrhea, hemolytic uremic syndrome, and ischemic colitis
What 2 bacteria can cause HUS? How? Clinical manifestations?
- Shigella and more commonly, EHEC (6-9% of EHEC cases -> accounts for >90% of HUS in children)
1. One of the main causes of AKI in children <3 - HOW: shiga toxin absorbed from inflamed GI mucosa into circulation, and alters endo cell function of sm blood vessels and kidney epithelium -> platelet activation and aggregation + damaged RBC’s that are lysed (schistocytes)
- CLINICAL: microangiopathic hemolytic anemia and thrombocytopenia 5-10 days after onset of diarrhea
1. AKI w/dialysis required in >50% pts (most regain kidney function)
2. Neuro sxs (seizures, somnolence): 25%
3. Mortality rate of about 5%

How is EHEC diagnosed and treated?
- DIAGNOSIS: Sorbitol-MacConkey agar
1. 0157:H7 strain does NOT ferment sorbitol: colonies will be white/translucent (image)
2. Other EHEC/E. coli colonies will be red/pink
3. PCR or ELISA can detect Shiga toxin (in stool) - TX: supportive care + monitoring for complications
1. Avoid anti-diarrheals (INC risk of systemic cxs)
2. AB’s are NOT beneficial, and may predispose to HUS by inducing more Shiga toxin release -> basically CONTRAINDICATED
How is EIEC transmitted? Pathogenesis?
- Similar to Shigella: causes similar disease
1. NO toxins produced - Transmitted via food/water and person-to-person contact
- PATHOGENESIS: invades intestinal cell, multiplies IC, and extends into adjacent intestinal cells
- Most common in young children in developing countries
What are the basics of Salmonella? Subtypes?
- G(-) bacilli, non-lactose fermenting, produces H2S (unlike shigella)
- Salmonella enterica serotype Typhimurium (formerly S. typhi) and nontyphoid Salmonella
1. S. enterica is the causative agent of typhoid fever, and does NOT cause gastroenteritis
2. S. paratyphi is another species that can cause illness similar to Typhoid fever (also does NOT cause gastroenteritis)
3. Non-typhoid Salmonella, most commonly S. enteritidis, causes salmonellosis, a significant source of gastroenteritis from food poisoning
What are the sources of S. enteritidis?
- Dairy products
- Meat
- Poultry and eggs
- Pet turtles, lizards, other reptiles
- Human-to-human
What is the pathogenesis of S. enteritidis?
- Organisms attach to M cells, and are endocytosed through a complex pathway
1. Virulence genes encode a type III secretion system capable of transferring bacterial proteins into M cells and enterocytes
2. Bacterial proteins trigger endocytosis and allow bacterial growth within endosomes - Bacteria cross basal membrane and enter lamina propria -> inflammatory response occurs
1. S. enteritidis also kills macrophages

What is the clinical presentation of Salmonellosis? Dx?
- CLINICAL: incubation period 1-3 days
1. N/V, diarrhea (can be bloody), crampy abdominal pain + fever in 50%
2. Illness lasts 3-4 days
3. 5% devo invasive disease: bacteremia, endo-vascular infections, endocarditis, osteomyelitis (SICKLE CELL) -> predilection for aortic plaques, bone prostheses (likes to cling to, infect these)
a. Note: Shigella does NOT do this
4. Can also develop reactive arthritis - DX: routine stool culture
What is the tx for Salmonellosis? Who is it indicated for?
- Not required for healthy people between 2 and 50 years (self-limited, and will resolve on its own)
- Tx INDICATED FOR those at-risk of disseminated or invasive disease:
1. Immunocompetent patients w/severe infection requiring hospitalization
2. Those w/known or suspected atherosclerotic plaques and endovascular/bone prostheses
3. Immunocompromised (HIV, those on steroids or o/immunosuppressants), sickle cell disease - TX: Flouroquinolones -> susceptibility testing should be performed
What is the causative agent of Typhoid fever? Transmission and epi?
- CAUSATIVE AGENT: S. enterica serotype Typhi
1. S. paratyphi can cause a similar illness - Humans are sole reservoir; TRANSMISSION occurs person-to-person (fecal-oral, infected food handler) or via contaminated food/water
- EPI: more common in children and young adults than older patients
1. Most prevalent in impoverished, overcrowded areas with poor access to sanitation
2. 80% US cases in travelers to countries where typhoid fever is endemic (South-central Asia)
3. Outbreaks in the U.S. most often foodborne



























